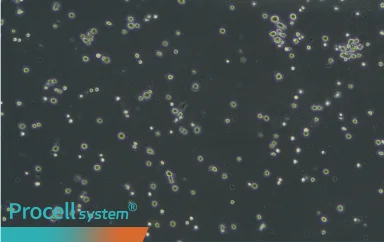
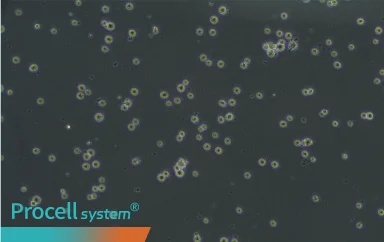

Selecting the Appropriate Cell Dissociation Reagent
| Trypsin | Recombinant Trypsin | Accutase | |
|---|---|---|---|
| Source | Animal-derived (porcine) | Animal origin–free | Animal origin–free |
| Buffer | PBS / D-Hank’s | DPBS | DPBS (Ca2+- and Mg2+-free) |
| Activity | Concentration-dependent dissociation strength | Gentle, effective | Gentler, high efficiency |
| Inactivation | Serum or trypsin inhibitor solution | Inactivation by dilution | No inactivation required |
| Higher cell viability | √ | √ |
Note: For applications involving stem cells, primary cells, or surface marker analysis, gentle dissociation systems are preferred.
Product Portfolio
Trypsin is one of the most commonly used enzymes for dissociating adherent cells and tissues. Procell Trypsin Solution maintains consistent, batch-to-batch performance.
| Product Name | Cat. No. | Size | Storage Condition |
|---|---|---|---|
| 0.05% Trypsin Solution, dissolved in PBS | PB180218 | 100 mL | -5--20℃ |
| 0.05% Trypsin Solution, with EDTA, dissolved in PBS | PB180219 | 100 mL | -5--20℃ |
| 0.05% Trypsin Solution, dissolved in D-Hank's | PB180220 | 100 mL | -5--20℃ |
| 0.05% Trypsin Solution, with EDTA, dissolved in D-Hank's | PB180221 | 100 mL | -5--20℃ |
| 0.05% Trypsin Solution, with EDTA, phenol red, dissolved in D-Hank's | PB180222 | 100 mL | -5--20℃ |
| 0.25% Trypsin Solution, with phenol red, dissolved in D-Hank's | PB180224 | 100 mL | -5--20℃ |
| 0.25% Trypsin Solution, with EDTA, dissolved in PBS | PB180225 | 125 mL/500 mL | -5--20℃ |
| 0.25% Trypsin Solution, with EDTA, phenol red, dissolved in D-Hank's | PB180226 | 125 mL/500 mL | -5--20℃ |
| 0.25% Trypsin Solution, with EDTA, dissolved in D-Hank's | PB180227 | 100 mL | -5--20℃ |
| 0.25% Trypsin Solution, dissolved in PBS | PB180228 | 100 mL | -5--20℃ |
| 0.25% Trypsin Solution, with EDTA, phenol red, dissolved in PBS | PB180229 | 100 mL | -5--20℃ |
Recombinant Trypsin Solution is animal origin–free, provides mild dissociation, and effectively replaces conventional animal-derived trypsin.
Accutase Cell Detachment Solution is a multi-enzyme dissociation solution with proteolytic and collagenolytic activities, suitable for cells sensitive to dissociation conditions.

Gentle Dissociation

Efficient Separation

Preservation of Cell Viability

Protection of Surface Antigens
| Product Name | Cat. No. | Size | Storage Condition |
|---|---|---|---|
| Accutase Cell Detachment Solution | PB180201 | 100 mL | -5--20℃ |
EDTA chelates divalent cations (e.g., Ca2+ and Mg2+), disrupting calcium-dependent adhesion. It is applicable for preserving cell surface molecules and commonly used with Trypsin Solution at defined ratios.
Validation of Cell Dissociation Reagents
· 0.25% Trypsin Solution
0.25% Trypsin Solution, with EDTA in PBS (Cat. No.: PB180225) was used to dissociate 293T and NCI-H358 cells.Digestion for 2 min in 293T cells and 5 min in NCI-H358 cells enabled uniform detachment with intact morphology. After reseeding and 24 h of culture, cells showed normal morphology and good adherence.
| Cell name | Before digestion | After digestion | Incubate for 24 h after digestion |
|---|---|---|---|
| 293T |  |
 |
 |
| NCI-H358 |  |
 |
 |
Note: Digestion time may vary depending on cell condition; the times provided above are for reference only.
· Recombinant Trypsin Solution
Recombinant Trypsin Solution, with phenol red (Cat. No.: PB180241) was used to dissociate Rat Umbilical Cord Mesenchymal Stem Cells. Digestion was completed rapidly, and extended incubation had no significant effect on cell viability or morphology.

Before digestion |
After digestionfor 1-3 min |

Incubate for 48 h after digestion for 1-3 min |
After digestion for 30 min |

Incubate for 48 h after digestion for 30 min |
· Accutase Cell Detachment Solution
Accutase Cell Detachment Solution (Cat. No.: PB180201) was used to dissociate Rat Bone Marrow Mesenchymal Stem Cells. After 1 min, cells detached uniformly with preserved morphology. Cells were then seeded into 6-well plates at a 1:3 ratio. By day 3, cultures reached full confluence, yielding > 3×106 cells. Flow cytometry confirmed >95% positivity for CD44 and CD90.
| Before digestion | After digestion |
|---|---|
 |
 |
| Flow cytometry(CD44+ 99.99%;CD90+ 96.78%) | |
|---|---|
 |
 |
FAQs
-
How should Trypsin Solution (with EDTA) be stored?
AnswerStore at -5℃ to -20℃. Aliquot into small volumes, use immediately after thawing, and avoid repeated freeze-thaw cycles.
-
How long can thawed Trypsin Solution be stored?
AnswerThawed Trypsin Solution can be stored at 2-8℃ for up to approximately 1 week. Enzymatic activity gradually declines under non-frozen conditions and may be further affected by repeated handling. Variations in cell adhesion strength may also impact dissociation efficiency. For consistent results, aliquot and minimize repeated use.
-
Can Recombinant Trypsin Solution digestion be stopped using serum-free or serum substitute media?
AnswerYes. Recombinant Trypsin Solution does not require inhibitors and can be inactivated by dilution. Serum-free media can be used, though at higher cost. Typically, dilution with a cell buffer or basal medium is recommended.
-
Does Accutase Cell Detachment Solution require inactivation after dissociation?
AnswerNo. Accutase Cell Detachment Solution does not require additional washing or inactivation steps.



